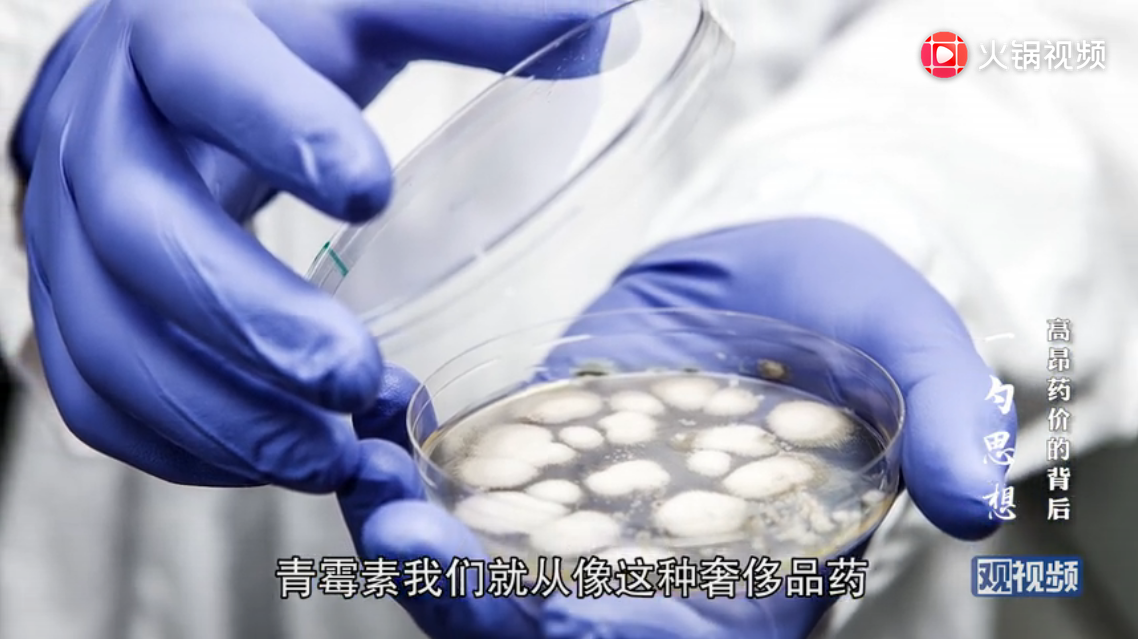
點擊查看大圖

李玲:中國製造世界領先,為何製藥卻比不過印度?
【文/ 李玲】
最近的醫改可能大家也注意到了,在提速。
2018年12月8日有一個叫“4+7”的帶量採購,就是四個直轄市加上七個副省會城市——中國最具購買力的11個城市——集中起來採購藥品。帶量採購的效果非常的好,因為這次採的二十多種藥,最高的降了95%,平均降幅超過60%,而且都是通過一次性檢驗的,也就是説是質量可靠的藥。

藥企特別特殊,全世界的藥企都是“巨無霸”的壟斷,因為藥企最大的成本是研發。目前研發一個新藥,國際上大概要二十億美元的研發成本,再加上十年的時間,所以這個企業要是沒有體量的話,是不可能經受得起這樣的一個研發成本和時間。如果老百姓對着這樣一個全球壟斷的藥企去買藥,你根本談不下藥價來。
所以這些年醫改,我們從過去單個醫院買藥,到國家省級層面招標採購,其實藥價都下不來。在這些年醫改的經驗教訓的基礎上,終於國家出手了,用國家的力量,用量來換價——就是你降了價以後,就進我的醫保了,而且我把三分之一的全國市場給你。這樣的話是雙贏,老百姓得實惠了,而生產藥品的企業也保持了合適的利潤。
我們還有一種選擇,就是所謂的仿製藥。
《我不是藥神》這個電影相信大家都看了,其實印度現在確確實實是全球生產仿製藥做得最好的,而且仿製藥不是假藥,仿製藥是真正通過評議的、一致性檢驗的,不僅僅是廉價,實際療效是一致的。

我想大家肯定有興趣知道,印度怎麼能生產出這麼多好的仿製藥?畢竟要説工業,印度跟我們比差遠了。其實我想大家不知道的是,印度是從咱中國學來的。七十年代,它來中國學習,一下就學到了真經——他發現中國人為什麼能看得起病,就是自己造藥。
當時我們就是造仿製藥的,過去傳統的那些所謂低價藥都是國家組織起來仿製的,如青黴素,我們就從“奢侈品藥”最後搞成了“白菜價”,一分錢也治。所以印度回去以後,它其實是以國家的力量在推動仿製藥的生產。
印度的法律不保護專利,但是它保護仿製專利,就是你把這個藥仿製出來了,工藝這套我保護你。因為我們都知道,知識產權是為了鼓勵創新,但是在藥這個行業,它有一個特殊性——一旦藥研發出來,如果它是能救命的,但因為經濟原因吃不起,這是不人道的,所以世界衞生組織是允許強制仿製的,簡稱“強仿”,但條件是人口眾多,經濟發展水平低。

印度是滿足這些條件的,所以跨國公司跟印度打官司打不贏,所以四十年以後,仿製藥造得最好的是印度。美國每年一半以上的藥都是從印度進口的——美國是最大的原研藥發明生產地,而它的老百姓也是吃不起原研藥的,因為原研藥太貴了,它也從印度進口藥。
讓我們感到很慚愧的是,中國製造打遍全天下(中國現在有最完整的工業體系,幾乎什麼都可以中國造),但就是製藥,以及跟看病連在一起的醫療、器械、耗材、設備,幾乎全是進口的——我們藥大概70%左右靠進口,器械設備90%多,所以它的價格一定是昂貴的。

所以,現在國家來組織,已經是一大進步,只有國家才有這個市場的力量。第一步就是以市場來壓價。我覺得這只是救急辦法,還是貴,格列衞降一半的話還得一萬多,是二百塊錢的五十多倍,然而我們目前還沒有生產能力。所以第二步,我覺得一定要國家牽頭,像牽頭談判降藥價一樣,下一步應該是國家牽頭生產,無論是原研藥還是仿製藥——可能第一步是仿製藥,快一些,然後生產原研藥。
這個問題也是很好玩的,實際上你看一看國家“十一五”、“十二五”、“十三五”五年規劃,生物製藥藥品一直是中國轉型升級的一個重中之重。但是為什麼不能落地?這可能是我們要問的問題。
我們也做了一點點研究,發現其實它和我們國家整個經濟結構變化有關。過去是由中國的化工部管整個製藥的,有一個牽頭部門來落實這個規劃,但是現在我們只有一個部,叫工業與信息化產業部,所有的歸這一個部在管。我也去問過工業和信息化產業部,沒人管;也就是説,我們整個製藥工業基本上是靠行業在自我運轉,好像缺國家的一隻手能落下去。

我們的企業太散了,它們沒有能力做研究,包括仿製藥要造出好的來,也是要做研究的。所以我相信,隨着醫改的深入,我們國家未來會帶量採購,會提升醫藥工業的集中度。另外,我們的藥最多的成本是在流通,這其實是不創造效益的,所以要把流通的成本給擠壓掉,讓我們的製藥企業有更多的利潤,這樣它才能做研發。
仿製藥以及原研藥的研發,一定是我們未來經濟升級中的一個重頭,這樣的話才能在未來讓我們老百姓吃得上好藥,而且吃得起好藥。
本文系觀察者網獨家稿件,未經授權,不得轉載。